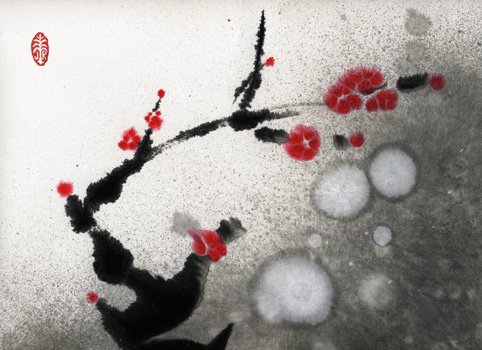
Moonblossom: original ink brush painting by Joan Relke

Landscapes |
|||
![]() |
![]() |
![]() |
![]() |
| Moonblossom #8 Sumie ink on rice paper 31 x 25 cm $150.00 |
Bamboo Sumie ink on rice paper 30 x 23 cm sold |
Moon on Bamboo #1 |
Asemic Moon Sumie ink on rice paper 24 x 30 cm $125.00 |
Cats |
![]() |
![]() |
![]() |
![]() |
| Moon on Bamboo #2 Sumie ink on rice paper 22 x 29 cm $150.00 |
Brancusi Sumie Ink on Rice Paper 23 x 31 cm $150.00 |
Minette #1 Sumie ink on rice paper 24 x 32 cm $150.00 |
Minette #2 Sumie ink on rice paper 24 x 32 cm $150.00 |
Female Imagery |
![]() |
![]() |
![]() |
![]() |
| Cat #4 Sumie ink on rice paper cm $120.00 |
Eve Sumie painting and photo on watercolour paper 29 x 22 cm $130.00 sold |
Pythia #2 Sumie Ink and photo on Watercolour paper 22 x 29 cm $150.00 |
Inner Truth #3 Sumie ink and photo on rice paper 29 x 22 cm sold |
![]() |
|||
Shadow Blossom |
|||

Original ink brush paintings of Landscapes, Cats, and Female Imagery.
The Sumi-e ink brush painting technique developed from Chinese calligraphy. The application of brush writing as early as the 6th Century CE in China evolved into the characteristic expressive and spontaneous qualities of Chinese and Japanese ink brush painting.
The desire of the painter is not so much to represent accurately the forms and shapes in landscape, portraiture, still life, and animal paintings. Rather, the painter desires to capture something of the essence of the object as well as the character of the painter.
The Sumi-e or ink brush painter will work from imagination rather than copy from living examples. After immersion in the subject, the artist applies the brush in a meditative and spontaneous movement, which can take only a few seconds to execute. Years of practice are required for the result to be satisfactory.
Presence of mind, equanimity, solitude, and focus are cultivated during the painting experience, creating a meditative atmosphere in which the mind and soul of the artist is as much the work of art as the result on the paper.
Materials include ink created from pine soot or oil soot; paper made from cotton and bamboo; and brushes made from animal hair, such as wolf, sheep, rat, and badger, with the different hair producing different results. As well, pigments are used sparingly, with the most frequent compositions being monochromatic black, grey, and white.
More information on Chinese and Sumi-e painting:
Wikipedia